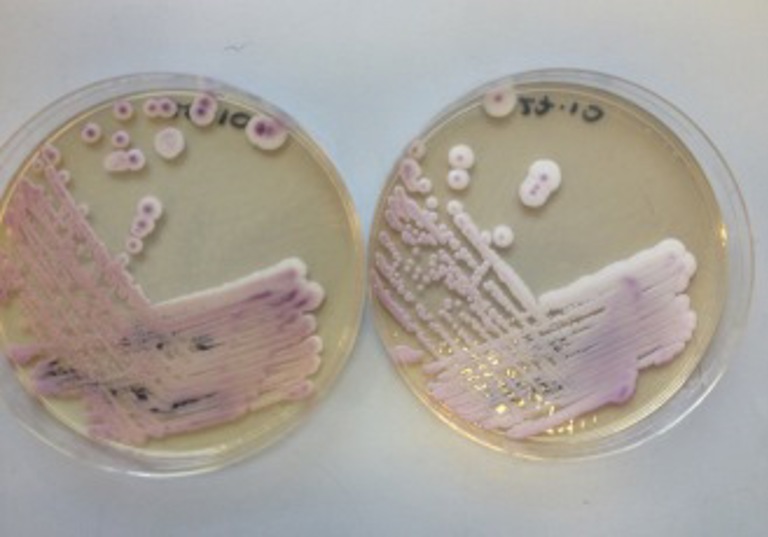

Neisseria gonorrhoeae Cepheid Diagnostic Escape Mutant Strains
In June 2025 UKHSA identified a Neisseria gonorrhoeae strain that produced a false‑negative result on the Cepheid Xpert® CT/NG test. The patient was successfully treated, and no onward transmission was identified. However, whole genome sequencing revealed the strain was missing both genetic targets required for detection by the assay, due to a recombination event with Neisseria meningitidis.